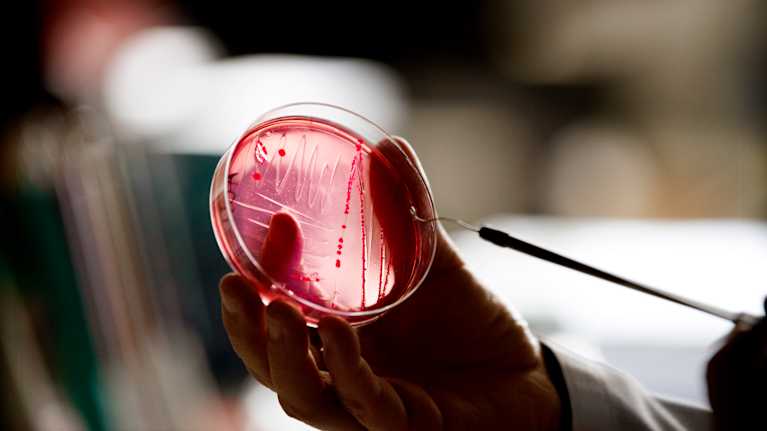
En person håller i en petriskål med ett prov, förmodligen bakteriekultur.

Globalt är en av sex bakterieinfektioner resistent mot vanlig antibiotika.
Öppna bildvisare
Antibiotikaresistenta bakterier utgör ett växande globalt hot mot hälsan. Arkivbild. Bild: Tiina Jutila / YleLyssna (du hör en artificiell röst) 2:28
Antibiotikaresistens är ett av de största globala hoten mot folkhälsan.
Globalt är en av sex bakterieinfektioner resistent mot vanlig antibiotika, uppger Institutet för hälsa och välfärd THL, och Säkerhets- och utvecklingscentret för läkemedelsområdet Fimea, i ett pressmeddelande.
Det försvårar behandlingen av infektioner och ökar dödligheten.
Årligen uppskattas 4,7 miljoner dödsfall vara kopplade till bakterierelaterad antibiotikaresistens.
Antibiotikaresistens innebär att en bakterie kan motstå antibiotika, vilket leder till att antibiotikan inte har någon effekt vid behandling av infektioner.
Andra mikrober, som virus och svampar, uppvisar också resistens mot läkemedel som används för behandling. Därför talar man numera ofta om antimikrobiell resistens.
Att överanvända antibiotika och andra antimikrobiella läkemedel påskyndar uppkomsten och spridningen av läkemedelsresistenta smittor.
Enligt Världshälsoorganisationen WHO har antibiotikaresistensen ökat med över 40 procent mellan åren 2018 och 2023.
Resor ökar spridningen
I Finland är situationen god och antimikrobiell resistens förekommer betydligt mindre än i många andra europeiska länder.
Åtgärder för at bekämpa antibiotikaresistens har vidtagits i Finland sedan början av 90-talet.
Enligt en färsk rapport har ändå andelen antibiotikaresistenta bakterier ökat också i Finland.
Resor utomlands ökar spridningen av resistenta bakterier mellan länder. Speciellt i tropiska områden ökar resistensen snabbt.
Efter en resa till tropikerna bär 20-70 procent av resenärerna bakterier som är resistenta mot viktiga antibiotika.
För att förhindra spridningen av resistenta bakterier på resor är det viktigt att sköta om handhygienen, dricka enbart flaskvatten och se till att ha nödvändigt vaccinationsskydd inför resan.
Antibiotika ska inte köpas utan recept, vid sjukdom utomlands ska man uppsöka läkare.
I dag, den 18 november är den Europeiska antibiotikadagen. THL och Fimea deltar i kampanjen.
Källa: Institutet för hälsa och välfärd (THL), Fimea